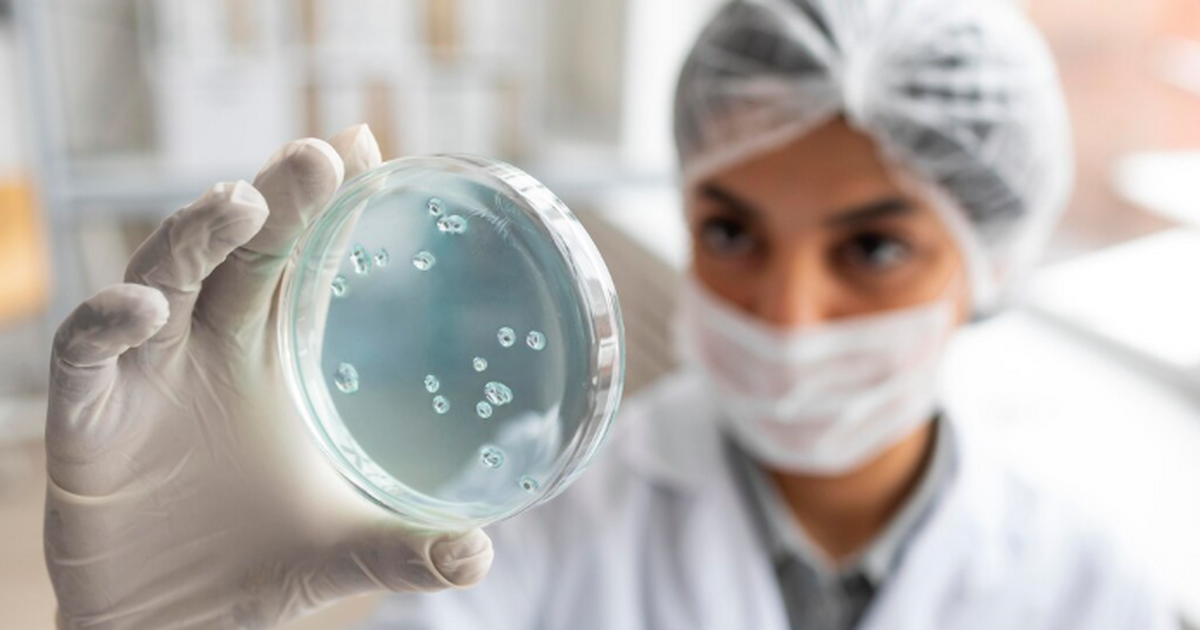
Учёные Томского государственного университета в...

Пробиотики нового поколения вызвали опасения у ученых ТГУ
freepik
Учёные Томского государственного университета выразили обеспокоенность безопасностью пробиотиков нового поколения. Об этом сообщили в пресс-службе вуза.
Речь идёт о так называемых NGP-пробиотиках — специально разработанных микроорганизмах, которые ранее не применялись в пищевой или фармацевтической промышленности. В университете отметили, что такие разработки вызывают вопросы, связанные с геномной стабильностью и возможными рисками для организма.
Как пояснил профессор Биологического института ТГУ Алексей Чурин, эти пробиотики создаются для лечения конкретных заболеваний и предполагают направленный терапевтический эффект. При этом ожидается, что при правильном применении они могут быть полезны для пациентов.
Учёные напомнили, что традиционные пробиотики, такие как лакто- и бифидобактерии, считаются безопасными для большинства людей и могут положительно влиять на пищеварение и иммунитет. Однако даже они в редких случаях могут вызывать осложнения у людей с ослабленным иммунитетом.
Отдельной проблемой специалисты назвали качество продукции на рынке. По данным ТГУ, встречаются случаи неверной маркировки, отсутствия жизнеспособных культур и несоответствия заявленных эффектов. В вузе считают, что усиление контроля качества поможет снизить риски для потребителей.
Больше новостей и эксклюзивных видео смотрите в канале Самара Онлайн 24 в MAX.
Читайте также:
- Пасха-2026: яйца цвета бургунди с блёстками — топовый праздничный тренд, который удивит всех
- Делаем 21 раз в месяц: Именно эта привычка может снизить риск рака простаты
- ИИ следил за моим смартфоном неделю — и раскрыл правду, к которой я не был готов
- Рабочую неделю сокращают до 4 дней — что это значит для сотрудников и экономики России
- Альтернатива Telegram найдена: В России резко набирает популярность новый мессенджер KakaoTalk


